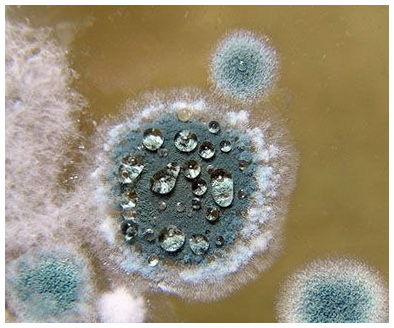
post image

Ну и я, чтобы быть в тренде😀 сохраню здесь 😏
#историяродов
🔞 возраст на момент родов -25
👽 токсикоз - немного во 2 триместре
⚖️ вес до беременности - 49,5
💪🏼 прибавка - 11,2
💃 общее состояние - супер
🏩сохранение - да, перед родами, лежала в 18 отд Пироговки
📆 ПДР - 02.01.2017
📅 дата родов - 16.12.2016
👶пол - девочка
🆚 вес\рост - 2830/49
🏤 вес при выписке - 2782
⏰ время - 10:40
🏥 РД - Пирогова
📆 дата поступления - 14.12.2016
👩⚕️ ЕР\КС - ЕР
💊 Анестезия - нет
🏨 дата выписки - 23.12.2016
🔪 Эпизиотомия - нет
💦 Амниотомия - нет
🆘 Разрывы - да, внутренние маленькие
💉 Окситоцин - нет
😭 Схватки - примерно 2 часа
😤 Потуги - да
🌀 Обвитие - нет
📶 Апгар - 8-9
🚮вес после родов- 56
🆕 вес сейчас - 52
🍼 ГВ\ИВ - ГВ
🚻 Хочу ли я ещё? - годика через 3-4 за сыночком✌️

Пелёнка🙈🙊
Вот уже 3ю неделю отучаю свою Мышку(3,5 месяца) от пеленки. Днём все хорошо, спит. А ночью, почти всегда, машет руками, ударяет себя, начинает капризить, но не просыпается, дерёт ушки, чешет глазки. Я и ручки убирала и грудь давала, но проходит 5-30 минут и опять 25! "Так пеленай" - скажете вы. Но с пелёнкой сложно пропукивается. И я переживаю, что она так и не привыкнет к ручкам и я её до года пеленать буду😳😯😟 Как представлю-лето, жара, а мне ее в пелёнку мотать... Бррр...Спят же как-...
Очень нужна помощь 🙏🙏🙏!
Летом сняли квартиру со свежим ремонтом, все абсолютно новое! Были на 7 небе от счастья, и хозяева хорошие. Заметила, что одежда в шкафу на дальних полках влажная и холодная. 😕Достала все, а там армагедон! 😱😱😱Стена шкафа мокрая и начала появляется плесень.😵 Оказалось, что стена за шкафом с трещиной, от куда дует сквозняк и появился грибок вследствии конденсата😱. Хозяева обещают летом, когда мы поедем на дачу все отремонтировать! Но у меня началась паника! У меня 3 месячн...

Мамарный Тест💓
Только что открыла для себя, что существует такой тест. Если б знала в первую беременность проверила бы 100%, т к родила только на 41 неделе😀
"Существует так называемый «мамарный тест» для определения готовности женского организма к родам.
Утром,когда вы спокойны,,нет тренировочных схваток,тонуса или другого дискомфорта ,👉срок больше 37 недель👈 сядьте или лягте в удобную позу, расслабьтесь, рядом поставьте часы- секундомер. Раздражайте соски и ареолы пальцами 5-6 раз по 1 минут...